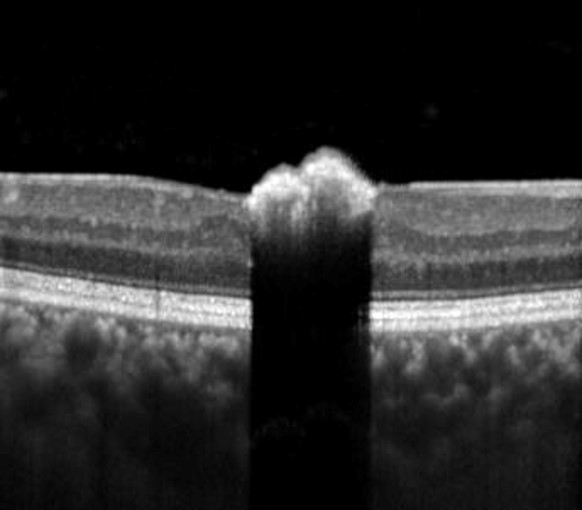

Overview
A CSHRPE is a rare benign hamartoma of the RPE. It may be associated with vitreoretinal traction, exudation, feeder vessels and pigmented vitreous cells.
Funduscopic features include a focal, dark pigmented nodular lesion often found within the macular region.
OCT imaging shows an elevated hyper-reflective lesion within the inner retina with deep posterior optical shadowing.
Fundus autofluorescence imaging shows corresponding hypo-autofluorescence.
Case Examples
-
Case 1
A 50 year old asymptomatic Middle Eastern male with best corrected visual acuity of 6/7.5 (20/25) in the right eye.
-
Case 2
A 38 year old asymptomatic Caucasian male with best corrected visual acuity of 6/6 (20/20) in the right eye.
-
Case 3
A 16 year old asymptomatic Asian female with best corrected visual acuity of 6/6 (20/20) in the left eye.
Differential Diagnosis
References
Ly, A. Nivison-Smith, L. Hennessy, M. Kalloniatis, M. (2015) Pigmented Lesions of the Retinal Pigment Epithelium, Optometry and Vision Science: Volume 92 - Issue 8
Shields et al., 2003. Congenital simple hamartoma of the retinal pigment epithelium: a study of five cases